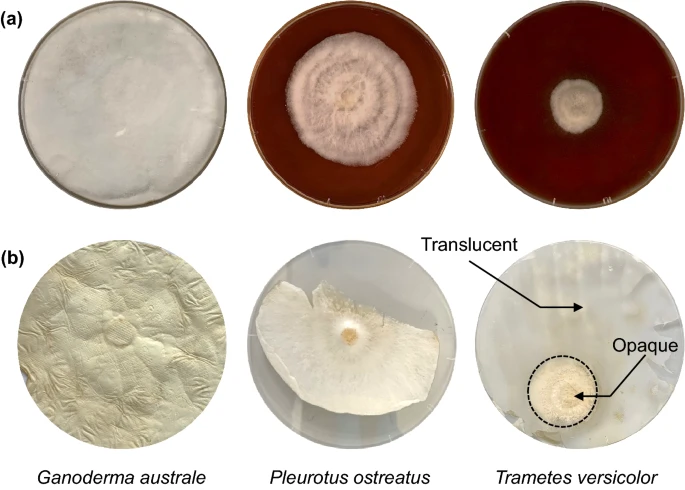
生长速率、微观结构特性和生化组成对菌丝体真菌热稳定性的影响 2 kr68
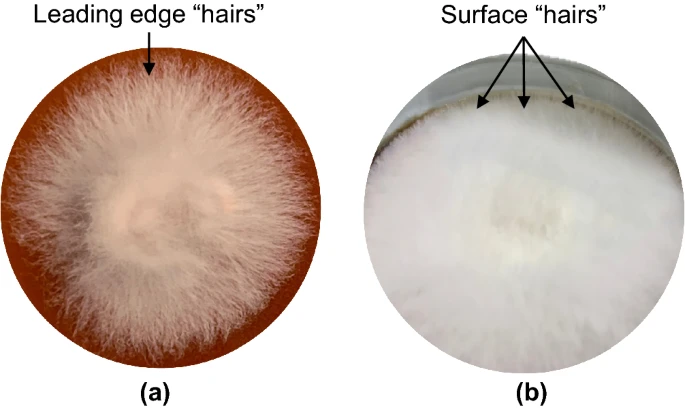
生长速率、微观结构特性和生化组成对菌丝体真菌热稳定性的影响 3 8eher

Scan the WeChat code to contact us

Scan the WeChat code to contact us



摘要
菌丝体真菌表现出阻燃特性。培养基对真菌生长速率、生化成分和微观结构特性及其与热性质关系的影响尚不充分。本文证明,糖蜜可以支持非致病性担子菌门真菌物种的生长,这些真菌产生具有潜在防火特性的生物衍生材料。扫描电子显微镜和傅里叶变换红外(FTIR)光谱仪被用于探究糖蜜生长菌丝体的微观结构和生化特性。通过热重分析与FTIR结合,实时演化气体分析,评估了糖蜜供养菌丝体的热分解。还评估了热暴露后残留炭的形态和显微结构特征。材料表征使得建立糖蜜养分菌丝体的微观结构、生化和热特性之间的关系。本文全面探讨了三种在糖蜜中生长的菌丝物类热降解机制。这些研究成果推动了对控制真菌生长速率和产量的关键参数的认识,以及微观结构和生化性质如何影响菌丝体的热响应。
介绍
在载客车辆和住宅中使用结构高效的聚合物复合材料受严格的消防法规限制(例如材料可燃性和易燃性)1.聚合物复合材料在高温和氧化环境中会持续燃烧并燃烧2.燃烧的高分子复合材料会产生热量,可能通过基体软化、基体分解、分层开裂和纤维损伤,损害工程结构的完整性3.此外,燃烧的高分子会产生有毒气体和烟雾,如一氧化碳和部分分解的碳氢化合物(即碳烟),这些是大多数火灾相关死亡的主因4.2017年格伦费尔大厦火灾因使用了未达到消防安全标准的聚乙烯铝复合外墙板,造成72人死亡——主要由吸入浓烟引起5.同样,1985年曼彻斯特机场灾难中,燃烧机舱材料产生的浓密、有毒且刺激性烟雾造成了55人死亡中的48人,当时英国Airtours 28M航班因起飞发动机故障起火6.格伦费尔大厦火灾和曼彻斯特机场灾难只是众多火灾悲剧中的两个例子,凸显了理解聚合物火反应特性的重要性。
将阻燃剂(FRs)融入聚合物复合材料中,有效减轻燃烧反应,减少有毒气体和烟雾的体积 7,8.将FR集成到聚合物复合材料中有多种方法,包括利用纳米和微型FR颗粒修饰聚合物基体9热保护表面涂层的应用10以及使用本来阻燃聚合物如酚醛树脂11.多年来,卤素化合物因其高效的气相阻燃机制,是大多数聚合物系统的首选阻燃材料8,12 .不幸的是,卤素阻燃剂会释放腐蚀性和破坏臭氧的气体,限制其使用,或在某些司法管辖区导致其被清除 12,13.迄今为止,取代卤代苯的竞争主要由有机和无机磷及含氮化合物(包括聚磷酸铵)占据主导14三聚氰胺磷酸盐15戊三烯糖醇16膨胀化合物17碳基纳米材料(如碳纳米管、石墨烯)18金属盐19以及金属氢氧化物20.尽管无卤素FRs有效,但其广泛应用面临环境不友好的制造工艺、与危险材料(即碳基纳米材料)处理和处理相关的职业健康与安全问题,以及重金属浸出可能造成的环境破坏。相比之下,生物衍生的FR如菌丝体显示出符合阻燃性和可持续制造要求的环境友好FR潜力。然而,菌丝体的阻燃效能及其相应的阻燃机制尚不足以充分了解,难以为大规模应用提供信心。在培养菌丝体时,保持无菌环境至关重要,以防止其他病原体污染。在工业规模维持无菌生长环境可能具有挑战性。此外,由于不同的生长模式,批次变异性将使产品质量保证受到挑战。
菌丝体是真菌的营养部分,具有丝状菌丝。它可以以环境可持续的方式从有机废弃物转化(例如在环境条件下生产,无需加热),制成可生物降解且天然耐火的生物材料。由于细胞壁中含有几丁质、蛋白质和葡聚糖,菌丝体本身具有耐火性,具有极佳的热稳定性。几丁质聚合物链含有N-乙酰氨基葡萄糖,这是一种对生成NH至关重要的氮源3气体作为气相稀释剂,可以抑制燃烧反应21.几丁质和葡聚糖具有多糖本级生化结构骨架,提供碳,这对于产生具有热保护性的表面焦炭至关重要。菌丝体中富含半胱氨酸的蛋白质成分(如对硫素)含有二硫键,这些键在高温下分解生成促焦的二硫化氢(H2S) 分子 22,23.当用作易燃聚合物复合材料的热保护膜时,菌丝体热分解产生的残余炭化物起到热绝缘体的作用,保护底层复合材料基底。
研究人员已成功利用菌丝真菌向上再利用固体农业废弃物,如小麦谷物24稻壳25还有锯末26转化为耐火生物复合材料。然而,部分固体饲料仍未被菌丝体消化。部分消化的残留固体进料颗粒可能损害菌丝体生物复合材料的耐火性和机械性能。有限的研究探讨了以菌丝体真菌为养分的液体培养基(如糖蜜)的材料性质27.与固体饲料颗粒与生物复合材料密不可分地融合不同,液态饲料材料可以被冲洗掉。此外,在取回完全成熟菌丝体后,回收的液态饲料溶液可再次用于支持新鲜真菌的培养,尽管由于养分耗竭,生长速度会较慢。黑糖浆是一种糖精炼产生的废弃物,是一种潜在的液体饲料材料,但使用有限。糖蜜具有高生物量和必需营养素,在支持菌丝生长方面优于常用麦芽提取物27.此外,糖蜜含有草酸钙,分解后会转化为CaCO。3高温下的一氧化碳28.CaCO3进一步降解为CaO和CO。2.科罗拉多和科罗拉多2是不可燃气体,作为稀释剂,在火灾中熄灭燃烧反应。此外,CaO增强了残余表面炭的热绝缘效能,从而对底层聚合物复合材料进行热保护。然而,尽管糖蜜作为菌丝体饲料具有诸多潜在益处,但目前尚无研究其对真菌生长速率、生化成分和微观结构的影响,尤其是菌丝体的热反应和火反应特性。此外,在菌丝体作为阻燃或热保护层被集成进工程复合材料之前,必须对常见聚合物基晶进行比较分析。
该项目研究了糖蜜对三种非致病性担子菌门菌种的生长速率、质量产率及热特性的影响。扫描电子显微镜(SEM)和傅里叶变换红外(FTIR)光谱法被用于对原始(变性真菌)及热暴露后残留炭的形态学、生化和微观结构特性分析。通过热重分析(TGA)与FTIR接口进行实时演化气体分析,评估了糖蜜供养菌丝体的热分解。将糖蜜培养的菌丝体与小麦谷物饲养真菌的热稳定性进行了比较,以评估饲料类型和残留未消化饲料材料对热稳定性的影响。此外,糖蜜供给菌丝体的热稳定性与商业聚合物基体(环氧树脂)进行了基准测试,以评估其作为可生物降解复合材料基体的适用性。本研究成果推动了对控制真菌生长速率和质量产出的关键参数的理解,并建立了真菌微观结构、其生化特性与热稳定性之间的经验相关性。
材料与方法
1、真菌栽培
从RMIT大学真菌培养收藏(澳大利亚)取自三种真菌培养物:Ganoderma australe、Pleurotus ostreatus和Trametes versicolor,均生长在麦芽提取物琼脂上,作为接种剂。Molasses是从E&A Salce(澳大利亚)购买的。环氧树脂(双酚A和F)(West系统105)及相应的硬化剂(West系统206)由Gougeon Brothers Incorporated(美国)供应。
糖蜜(15克)溶于水(135克)中,制成10重量的糖蜜/水供水溶液。为防止污染,糖蜜/水溶液在121°C下消毒30分钟,然后冷却至室温。以20°C的糖蜜/水溶液(15毫升)转移到直径9厘米的无菌培养皿中。用无菌移液器底座从琼脂平板上切出一个直径6毫米的真菌培养物圆盘。接种剂置于培养物中心,内含15毫升糖蜜/水溶液,然后用对抗膜封口。每种真菌至少培养了三株复制标本。密封培养皿在受控环境(温度25°C;8小时白光周期)中孵育10天。在第4、7和10天同时拍摄了生长中的菌丝菌丝的照片。菌丝桡骨生长(厘米)2)是用ImageJ软件1.46r(https://imagej.nih.gov/ij/)估算的。
2、菌丝体与环氧样品制备
菌丝生长过程中形成的残留糖蜜和棕色胶状薄膜通过用流水冲洗30分钟,随后浸入温水(50°C)24小时,冲洗掉了采集的菌丝膜。菌丝膜被反复用水冲洗,以去除糖蜜进料溶液中残留的糖晶。米白色菌丝膜通过在真空袋压力(−1大气压)下在120°C的烤箱中烘干2小时而失活。干燥的菌丝膜被储存在密封塑料袋中,以防止大气水分吸收。环氧树脂和硬化剂按照制造商推荐的化学计量比混合,并在室温下固化24小时。室温固化环氧基体在60°C下后固化8小时,用于菌丝体的热稳定性基准测试。
3、化学分析
菌丝膜在室温下使用配备衰减全反射(ATR)透镜的Perkin Elmer(Spectra 100)傅里叶变换红外光谱仪进行表征。FTIR-ATR用于鉴定原始菌丝体中的官能团以及热降解后固体残余炭中的官能团。每个FTIR-ATR实验均采集32次4厘米扫描−1分辨率介于650至4000厘米之间−1并记录了平均频谱。FTIR光谱经过基线校正,吸收峰通过FTIR-ATR内置的Perkin Elmer光谱10.5.2软件分配。每种真菌至少记录了三个FTIR光谱。
4、热重分析(TGA)和演化气体分析(EGA)
热诱导质量损失和对演化气体的实时FTIR分析,通过TGA(Perkin Elmer STA 6000)与傅里叶变换红外光谱仪(Perkin Elmer Frontier)接口完成。菌丝膜在TGA实验前以60°C调理了3小时,以去除物理吸附的水分。选择60°C的调节温度是为了防止低分子量基团的不必要热降解。在典型的TGA实验中,菌丝体微粒或后固化并粉碎的环氧树脂(~12毫克)被放入氧化铝坩埚中。在流氮条件下,TGA炉的温度以每分钟30°C的速度在25至850°C之间提升2气体(20毫升/分钟)。连接TGA与FTIR的逸出气体转移管线保持在300°C,并持续注入氮2气体(流量50毫升/分钟)以防止挥发物冷凝。FTIR持续分析4000至400厘米范围内的气体−1波数范围为4厘米−1决心。在所有实验数据集中,使用空样本架进行TGA实验所得的基线曲线被扣除以补偿浮力。残余炭化率在600°C下采集。 每种真菌物种至少进行了三项实验。
5、微观结构与形态分析
菌丝体的微观结构和形态(热降解前后)通过配备能量色散X射线光谱仪(SEM–EDS)的扫描电子显微镜(FEI Qanta 200)进行表征,该仪由Aztec软件作。SEM图像在加速电压15 kV、5点大小和3000倍放大率下采集。原始菌丝体和TGA残留炭渣样品(在600°C采集)使用徕卡ACE600溅射涂层机,在8×10°C下进行溅射涂层−3MBAR实现了约5纳米的涂层厚度。通过使用ImageJ软件1.46r分析SEM图像,估算了菌丝径向直径。
结果与讨论
活菌和变性菌丝体物种的照片显示了明显的表面地形,如图所示。1. 南根芝的地形平坦蓬松,而Pleurotus ostreatus和Trametes versicolor则具有由放射状脊和谷地定义的起伏表面(见图)。1a)。在菌丝膜上观察到细小的毛状丝状,可能是表面活性且富含半胱氨酸的蛋白质(水膱素),通常由丝状真菌产生(见图)。2)水连蛋白层使菌丝通过降低表面张力或防止积水,突破空气-介质界面,同时保持渗透性,从而实现气体交换 22,23.第10天拍摄的南灵芝图像覆盖了培养皿的全部表面积,如图所示。1点。相比之下,生长相对缓慢的Pleurotus ostreatus和Trametes versicolor物种的不透明菌丝切面分别覆盖了培养皿表面的43%和7%。

菌丝膜通过高温暴露于高温下被热失活,如实验部分所述。变性菌丝体薄膜的图像见图。1b。热失活薄膜的表面质地因真菌种类而异。南风芝大多不透明,表面质地粗糙。相比之下,Pleurotus ostreatus和Trametes的变色胶片揭示了两个明显的同心圆区域;接种部位附近胶片几何中心有一块不透明且粗糙的区域,以及图中所示的较大、半透明且相对光滑的周边区域。1b,适用于Trametes versicolor。与Trametes versicolor一样,Pleurotus ostreatus也有较大的半透明切片。热失活后干质量产量最高的是南灵芝,其次是Pleurotus ostreatus,然后是Trametes versicolor,分别重168±2、77±2和32±3毫克。Pleurotus ostreatus和Trametes versicolor相较于南方灵芝的归一化质量产值分别为46%和19%。需要注意的是,半透明切片对整体干真菌质量产量的贡献微乎其微。
这三种真菌均展现出多孔(开放细胞状泡沫)管状菌丝网络,覆盖着连续的表层,如图所示。3. 光滑的表面层结构可能是热失活过程中疏水素层固结的结果。对三种菌丝体的元素分析显示,纤维菌丝网络与表层之间存在元素差异,前者钙浓度更高。糖蜜通常含有大量以草酸钙形式存在的钙。真菌生长过程中,钙被菌丝体吸收。草酸钙转化为CaCO的过程3,科罗拉多2一氧化碳有潜力改善菌丝体的热稳定性28.纤维菌丝网络的微观结构因菌丝种而异,如图所示。4. 南灵芝的菌丝(图。4a)融合在一起,较Pleurotus ostreatus中的更薄但密集排列(图。4b)和特拉梅特斯·维西科尔(图。4c)。琼斯等人。24报告称,Trametes versicolor 菌丝的融合大约需要18天的生长时间。本研究在菌丝纤维融合前的第10天采集了Trametes versicolor和Pleurotus ostreatus。南灵芝具有细小的纤维菌丝,朝特定方向生长。SEM表征显示Pleurotus ostreatus和Trametes versicolor不透明切片之间的显微结构差异显著。Pleurotus ostreatus 具有致密且增厚且生长模式随机的菌丝,而 Trametes versicolor 则有晶体碎片和随机生长。


Ganoderma australe(a, d)、Pleurotus ostreatus(b, e)和Trametes versicolor(c, f)原始菌丝体(上方)和残余红点鲑的菌丝形态(下方)。
利用傅里叶红外(FTIR)分析了热失活菌丝薄膜,以确定菌丝微观结构特征与相关生化结构之间的关系。对三种真菌不透明切片的FTIR光谱分析变化不大(见图)。5)。由于这三种物种都源自同一担子菌门,它们由几丁质、蛋白质和碳水化合物组成,形式为葡聚糖和多糖29.该物种的吸收带宽约为3330厘米−1对应于多糖中的O–H拉伸振动和/或蛋白质中酰胺官能团的N–H拉伸振动30.宽广且相对较弱的吸收带中心约为2850厘米−1以及2900厘米−1归因于几丁质、蛋白质和碳水化合物中的C–H拉伸。吸收峰值约为1630厘米−1被归为C=O拉伸(酰胺I或氨基酸)31,32,33,C=C拉伸(氨基酸) 31,34和/或N–H弯曲(类黄酮)34. 吸收带约为1545厘米−1在南灵芝中较为显著,Pleurotus ostreatus则被归类为N–H弯曲(酰胺II)或C–N拉伸(酰胺II) 30,35.三种物种的吸收带相对较弱,约为1317厘米−1(酰胺III C–N拉伸32;酚类O–H拉伸33),1150厘米−1(C–O拉伸声)30,35,36以及1030厘米−1(酒精 R–CH2——OH弯音;C–O弯音)36.大约760厘米处有一个弱红外活动带−1对于Trametes versicolor物种,则归因于与葡聚糖中多糖异头结构相关的骨骼振动37.

总体来看,三种真菌的FTIR光谱由五个不同的吸收区特征为N–H和O–H拉伸区(3700–3000厘米)−1),C–H拉伸(3000–2800厘米)−1),蛋白质酰胺(1750–1500厘米)−1),多糖(糖)(1200–950厘米)−1)和异头碳(900–750厘米)−1).FTIR光谱分析确认了几丁质、蛋白质和碳水化合物(即葡聚糖和多糖)的存在,这些物质都具有固有的阻燃特性21,38,39.吸收峰值为1750–1500厘米−1(蛋白质)和1200–950厘米−1(碳水化合物)可用于计算菌丝体中的蛋白质/碳水化合物比例。蛋白质与碳水化合物的比例会强烈影响菌丝体的热分解,因为碳和氮具有不同的阻燃机制。几丁质中的N-乙酰-d-氨基葡萄糖分子链会产生如NH等稀释气体3抑制燃烧反应 40,41.相反,富含碳的多糖(即几丁质和葡聚糖)促进形成具有热保护性的碳质炭酸42.水膦层中的分子内和分子间半氨酸二硫键可在高温下分解,生成促炭化的二硫化氢(H2S) 分子22.
尽管半透明切片对整体质量的贡献相对较低,但探索半透明与不透明菌丝材料之间的生化结构差异至关重要。不透明材料与半透明材料生化结构的变化会显著影响其热稳定性。图中仅展示了来自Pleurotus ostreatus和Trametes versicolor提取物的不透明和半透明材料的FTIR光谱。6 因为灵芝没有半透明材料。蛋白质峰下方整合面积的相对较低计算比值(1750–1500 厘米)−1)以及主要碳水化合物峰值(1200–950厘米)−1)表明半透明切片内N-乙酰-d-氨基葡萄糖含量(即几丁质)含量降低。富含碳的几丁质多糖含量降低会不利于碳质炭的生成,导致半透明材料的残余炭产量相对较低。

通过热重分析确定真菌种类生长速率、生化成分与热性质之间的关系。同时测量菌丝体的热重质量损失(TG)及其衍生热重质量损失率(DTG)剖面,如图所示。7. 对于Pleurotus ostreatus和Trametes versicolor,从不透明和半透明切片中提取了测试样品,以研究材料成分对热稳定性的影响。从Pleurotus ostreatus和Trametes versicolor物种不透明和半透明切片提取的样品具有明显的热降解特征。不透明材料的热稳定性优于半透明部分。不透明材料中较高的富碳几丁质含量,由FTIR光谱揭示(图)。6),可能是其优越热稳定性的原因。

由于不透明材料存在于所有真菌物种中,关于热稳定性的讨论集中在这种材料上。三种真菌的TG和DTG剖面显示,在主热降解阶段开始前,25至225°C之间发生了多级质量损失(8–15%)。鉴于所有菌丝体标本在TGA实验前立即在60°C下进行了3小时的调理,这种非典型的早期质量损失不能归因于物理吸附水的脱附。相反,低温质量损失被归因于低分子量(< 20 kDa)的水莆素层的热降解和挥发22.初始热降解阶段(25–225°C)之后是主热分解阶段(225–450°C),在此期间所有菌丝体物种均记录质量损失35%至45%。225–450°C之间的质量损失归因于真菌细胞壁的热分解,该壁由几丁质、氨基酸、碳水化合物(包括多糖)和葡聚糖组成。与南甘芝、Pleurotus ostreatus和Trametes versicolor物种相比,具有更高的热稳定性,这可能源于其1750–1500厘米处由强N-乙酰-d-葡萄糖诱导的FTIR吸收带显示出的较高几丁质含量−1.几丁质是炭化形成所必需的丰富元素碳来源。三种菌丝体均记录到在400至650°C之间显著的质量损失(6–14%),归因于初级碳质红斑的形成。主炭化物在低于800°C之前保持稳定。 超过800°C时,持续的热暴露导致进一步的质量损失(例如7–14%),产生二次碳质炭。次级碳质碳炭是初级碳酸在高温下交联形成固化三维网络的产物。Pleurotus ostreatus的次级残余红斑鱼产量最高,达到850°C(30%),其次是Trametes versicolor(22%),Ganoderma australe产量最低(20%)(见图)。7a)。值得注意的是,生长最快的南灵芝属是热稳定性最低的真菌物种。另一方面,温度最稳定的Trametes versicolor物种生长最慢。这些观测表明质量当量与热稳定性呈反比关系。真菌生长速度减缓可能为几丁质的建立提供时间,而几丁质进而促进炭疽的形成。生长速率和热性能对于选择用于高通量生产生物基阻燃剂的真菌物种至关重要。
虽然菌丝体的质量损失-温度分布存在一些差异(见图。总体而言,质量损失和质量损失速率表明其热降解机制和热稳定性相似。为确定热降解机制,使用了TGA接口的傅里叶变换红外光谱仪实时分析演化气体。由于三种真菌的进化气体FTIR光谱相似,仅讨论为南风芝收集的TGA-FTIR数据。图中展示了从南灵芝演化出来的气体在150、300、350、400和600°C等特定分解温度下的FTIR光谱。8 a。FTIR光谱在150°C下采集,显示了一氧化碳的释放2这可能归因于低分子量水膉的热氧化。在主要分解阶段开始时,约300°C时,FTIR气体光谱显示了H的存在2O,可能是低分子量烃类如CH4,微量一氧化碳2,以及NH3.对应CO的红外波段强度2, H2新罕布什尔州3低分子量烃类在分解温度350°C达到峰值(例如显著热分解阶段的尾端)。在350°C以上,FTIR强度随着温度升高而减弱,这从600°C下演化的气体几乎平坦的光谱可见一斑。 图中展示了三种气体在热分解温度350°C下演化的FTIR光谱。8B。三种真菌在强度上存在差异,但进化出的气体成分没有差异。稀释气体(即一氧化碳2, H2O和NH3在三种菌丝体的FTIR光谱中识别出的,对于抑制燃烧反应至关重要。当菌丝体与高易燃材料如烯烃聚合物结合时,它们可以促进灭火效果。

在600°C下收集的残余炭化物通过SEM和FTIR技术进行了表征,以阐明热降解机制。图中所示的南灵芝、Pleurotus ostreatus和Trametes versicolor的热曝光后SEM图像。4揭示了原始标本的可辨识微观结构变化。尽管菌丝横截面积减少,南叶灵芝仍保留了其融合且相互连接的菌丝微观结构(图。4d)。以Pleurotus ostreatus为例(图。4e)和特拉梅特斯·维西科洛尔(图。4 f),尽管菌丝截面因热导致物质流失显著减少,真菌物种仍保留了三维菌丝网络。菌丝细胞壁中高度热稳定的几丁质继续支持三维纤维网络,尽管菌丝丝直径减少24.这些结果与Jones等人报告的发现一致。24对于小麦饲养的Trametes versicolor,则在类似的热降解条件下使用。尽管热暴露后微观结构存在一些差异,三种不同真菌的残余炭化产率相似。这表明原始菌丝体的微观结构特征对其热分解机制的影响有限。这一观点得到了Jones等人报告的研究结果的支持。24他们证明了小麦饲养Trametes versicolor中生长时间相关的微观结构变化并未改变通过锥体量热器评估的火反应性质。
图中展示了从不透明菌丝体标本中提取的炭渣残基的FTIR光谱(即初级炭化)。9. 所有菌丝体物种均表现出以下吸收带;强烈且尖锐的山峰中心位于~1400厘米−1(C–H弯音)43以及~ 870厘米−1(C–H弯曲呋喃糖环)44,一个弱而宽的峰,中心位置为~1030厘米−1(C–O–C拉伸声)33,950–750厘米−1(葡聚糖中的苷键) 33,43以及一个弱但尖锐的峰,位于710厘米左右−1(C–H弯音)43.呋酮环可能归因于吡方糖因高温暴露导致的环链互变异构。三种物质回收的炭化物室温测得的FTIR光谱没有明显差异;进一步印证了微观结构变化对热降解途径和分解产物(包括残余碳酸)影响极小的发现。

在菌丝体作为阻燃剂被集成进工程复合材料之前,必须了解这种新型生物材料与常见复合材料基质(如环氧树脂)的区别。在这项研究中,生产力最高的菌丝体物种——南型灵芝(Ganoderma australe)被以环氧聚合物作为基准测试。图中绘制了南色灵芝和环氧聚合物的质量损失和质量差剖面,与温度关系相符。10. 环氧聚合物遵循两步热降解路径;100至250°C间质量损失约10%,300至500°C间约80%质量损失(见图。10a)。第一阶段的热质量损失归因于物理吸附水分和交联聚合物基体的脱吸。更显著的第二步则归因于环氧聚合物链的热分解。在250°C时,灵芝比环氧聚合物损失了4–5%的材料。在低于405°C的温度下,环氧聚合物的热稳定性优于南地灵芝。Pleurotus ostreatus和Trametes versicolor也存在类似的热降解特征,与Ganoderma australe相似。在温度超过405°C时,南向灵芝,以及由此可见的Pleurotus ostreatus和Trametes versicolor,其热稳定性优于环氧聚合物。真菌种类在600°C下产生了显著更高的初级残余炭化率(>30%),而环氧聚合物约为10%。

南风芝与环氧聚合物之间的热稳定性差异在质量差数据中更为明显(质量)南灵芝− 质量环氧树脂)与图中温度的关系图。10b。在低于405°C的温度下,环氧聚合物的热稳定性优于南风芝,这从负质量差可见一斑。在405°C以上,南风芝优于环氧聚合物,这一点通过正质量差计算得出。在405至785°C(绿色阴影)温度下,质量差-温度分布下的积分面积是25至405°C(红色阴影)计算值的两倍多。值得注意的是,交叉点左右两侧的集成温度范围(405°C)相同,表明南风芝整体热稳定性优于环氧聚合物。菌丝菌在相对高温下的热稳定性增强,可能得益于几丁质和炭化促进钙的衍生物,为设计生物衍生的热保护表面材料打开了一条道路,用于受火灾威胁的聚合物复合材料。当暴露于高辐射热通量时,聚合物复合材料暴露表面的温度可在几秒钟内升高超过400°C。菌丝保护层的热降解将在低于100°C时开始。 菌丝表面保护膜分解时,会产生固结的表面炭化物,用于热绝缘底层的原始但可燃聚合物复合材料。
很少有研究探讨糖蜜或类似液相饲料对菌丝体生长速率、产量及热稳定性的影响。当使用固体饲料材料生长菌丝时,部分消化的残留饲料无法与最终生物复合材料分离。残留的固体饲料可能对菌丝体生物复合材料的机械和火性能产生不利影响。因此,研究独立种植于固体小麦谷物和糖蜜中菌丝体种类热稳定性差异非常重要。Jones等人将糖蜜饲养的Trametes versicolor的热性能与在固体小麦谷物中种植的同一物种进行比较。24如图所示。11. 在低于250°C的温度下,糖蜜养殖的真菌质量不如小麦种植的标本。然而,在超过250°C的温度下,糖蜜喂养的真菌标本在热稳定性上更为稳定。与小麦谷物类似,糖蜜可以支持菌丝体真菌的生长,产生具有相当甚至更优热稳定性的生物材料,尤其是在高温(> 250°C)下。此外,虽然小麦颗粒与菌丝菌丝紧密结合,但多余的糖蜜可以被冲刷掉。琼斯等人。24证明小麦的热稳定性不如Trametes versicolor。因此,存在热稳定性较低的小麦颗粒24有可能降低菌丝复合材料的防火效能以及机械性能。此外,本研究证实回收的糖蜜溶液可以支持新鲜接种物的生长,尽管生长速率略有减缓。相比之下,无法回收剩余固体饲料以支持未来菌丝体培养。

在工业规模应用中,在装满糖蜜的浅托盘中生长的大片菌丝膜可以集成为火灾威胁的易燃材料和复合材料上的热保护表面层。菌丝膜可以作为牺牲材料,通过热分解在火暴露表面产生次生碳质炭。产生的表面炭可以减缓热量传导到下方的易燃基底,同时防止可燃挥发物泄漏到燃烧区。或者,菌丝体生物量可以被粉碎成微颗粒,然后混合到聚合物基质中。虽然微型 FRs 集成到聚合物中已经很成熟,但值得注意;向聚合物中添加菌丝粉或微纤维会增加粘度,从而引发材料加工问题。尽管如此,我们在论文中已证明,糖蜜是培养薄菌丝膜的可行原料,具有有前景的热稳定性和可能的阻燃特性。此外,研究应重点开发将菌丝膜整合进工业级防燃产品制造工艺的方法。
结论
有报道指出,一种环保的低价值糖加工副产物(糖蜜)升级再造为阻燃菌丝的方法。这项研究表明,液态糖蜜支持非致病性的担子菌门菌丝体(Ganoderma australe、Pleurotus ostreatus 和 Trametes versicolor)的生长。南灵芝生长最快,产生不透明菌丝膜,且质量产率最高。Pleurotus ostreatus和Trametes versicolor的质量产率较低,且产生的菌丝膜具有不透明和半透明切片。尽管形态和微观结构特征存在差异,但研究真菌物种的生化组成是可比的。本研究建立了菌丝体生长速率、微观结构、生化组成与热性之间的关系。
生长速率最高的真菌物种南灵芝(Ganoderma australe)是三种真菌中热稳定性最低的。不同的生长速率和不同的微观结构特征在有限程度上影响了三种物种的热降解(质量损失与温度的关系)。对进化气体和残留初级炭化物的类似FTIR光谱,表明三种真菌具有类似的热降解机制。菌丝体的热稳定性可能受几丁质含量控制,而其产量可能受真菌生长速率的影响。由糖蜜滋养的菌丝体产生的表面炭化比石油基环氧聚合物更多,表明真菌衍生生物复合材料可能被用作热保护膜。在糖蜜中培育的Trametes versicolor物种的热稳定性优于以小麦饲养的同类。本研究证明了生产具有优于环氧等商业聚合物的真菌生物材料的可行性。本文报告的研究成果将为新型可持续且阻燃生物材料的开发铺平道路。
参考文献